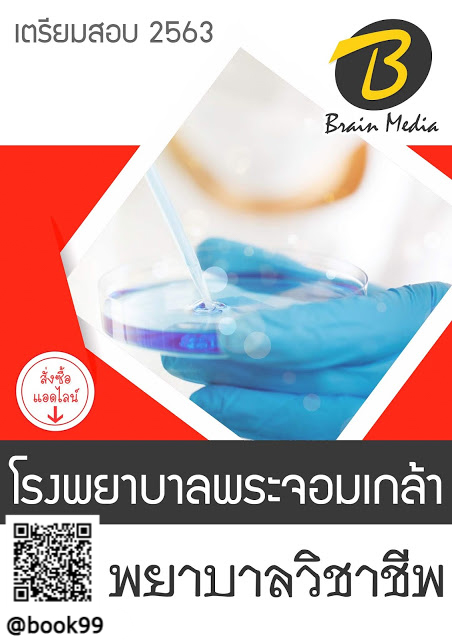

แนวข้อสอบ พยาบาลวิชาชีพ โรงพยาบาลพระจอมเกล้า
| จำนวนชิ้น | ส่วนลดต่อชิ้น | ราคาสุทธิต่อชิ้น |
| {{(typeof focus_pdata.price_list[idx+1] == 'undefined')?('≥ '+price_row.min_quantity):((price_row.min_quantity < (focus_pdata.price_list[idx+1].min_quantity - 1))?(price_row.min_quantity+' - '+(focus_pdata.price_list[idx+1].min_quantity - 1)):price_row.min_quantity)}} | {{number_format(((focus_pdata.price_old === null)?focus_pdata.price:focus_pdata.price_old) - price_row.price,2)}} บาท | {{number_format(price_row.price,2)}} บาท |
| {{ sub_option.name }} | - ไม่มีตัวเลือก - |
|
| คงเหลือ | ชิ้น | |
| จำนวน (ชิ้น) |
- +
|
|
|
ซื้อเลย หยิบลงตะกร้า ซื้อเลย หยิบลงตะกร้า คุณมีสินค้าชิ้นนี้ในตะกร้า 0 ชิ้น
|
||
|
|
||
| คุยกับร้านค้า | ||
| {{ size_chart_name }} |
|
|
| หมวดหมู่ | โรงพยาบาลพระจอมเกล้า | |
| สภาพ | สินค้าใหม่ | |
| เพิ่มเติม | ||
| สภาพ | สินค้ามือสอง | |
| เกรด | ||
| สถานะสินค้า | ||
| ระยะเวลาจัดเตรียมสินค้า | ||
| เข้าร่วมโปรโมชั่น | ||
รายละเอียดสินค้า
| ไฮไลท์ |
✔- ปรับปรุงเนื้อหาตรงตามประกาศสอบล่าสุด
✔- กระชับ ตรงประเด็น ครบจบในเล่มเดียว
✔- ฟรีไฟล์เสียง MP3 เทคนิคการสอบสัมภาษณ์
✔- เตรียมความพร้อมก่อนลงสอบสนามจริง อย่างมั่นใจ
รูปแบบการสั่งชื้อสินค้า **ฟรีค่าจัดส่ง**
✔- ไฟล์ PDF เล่มละ 380 บาท โหลดได้ ปริ้นได้ ส่งทางอีเมล์ ภายใน 5-30 นาที
✔- หนังสือ เล่มละ 680 บาท จัดส่งฟรี Flash Express 1-3 วันถึง
(เนื้อหาเหมือนกันทั้ง 2 รูปแบบ)
ติดต่อสอบถาม สั่งซื้อแนวข้อสอบเพิ่มเติมได้ที่
Line id: @book99 มี@ด้วยนะคะ
แอดไลน์เพื่อสั่งซื้อหรือขอดูตัวอย่างสารบัญจริงได้เลยค่ะ
|
| ข้อมูล |
น้ำหนัก
บาร์โค้ด
ลงสินค้า
อัพเดทล่าสุด
|
| รายละเอียดสินค้า |
แนวข้อสอบ พยาบาลวิชาชีพ โรงพยาบาลพระจอมเกล้า - ความรู้เกี่ยวกับโรงพยาบาลพระจอมเกล้า - แนวข้อสอบความรู้ความสามารถทั่วไป - แนวข้อสอบความสามารถด้านการคิดคำนวณ - แนวข้อสอบความสามารถทางด้านเหตุผล - แนวข้อสอบวิชาภาษาไทย, ภาษาอังกฤษ - แนวข้อสอบศีลธรรมและจริยธรรม - แนวข้อสอบเกี่ยวกับกระทรวงสาธารณสุข - แนวข้อสอบพระราชบัญญัติการสาธารณสุข พ.ศ. 2535 - แนวข้อสอบระเบียบกระทรวงสาธารณสุขว่าด้วยพนักงานกระทรวงสาธารณสุข พ.ศ. 2556 - แนวข้อสอบสิทธิประโยชน์ของพนักงานกระทรวงสาธารณสุขทั่วไป พ.ศ.2561 - แนวข้อสอบการใช้โปรแกรมคอมพิวเตอร์และเทคโนโลยีสารสนเทศ - แนวข้อสอบพยาบาลวิชาชีพ - แนวข้อสอบการปฐมพยาบาลเบื้องต้น - แนวข้อสอบการพยาบาลเวชปฏิบัติชุมชน - แนวข้อสอบกฎหมายวิชาชีพการพยาบาล - ความรู้ตามมาตรฐานการพยาบาลวิชาชีพ - ความรู้เรื่องการปฐมพยาบาลเบื้องต้น และส่งต่อผู้ป่วย - ความรู้ด้านการวิจัยทางคลินิก - แนวข้อสอบ สังคม เศรษฐกิจ การเมืองปัจจุบัน (กุมภาพันธ์) - แนวข้อสอบ สังคม เศรษฐกิจ การเมืองปัจจุบัน (มีนาคม)
- แนวข้อสอบ สังคม เศรษฐกิจ การเมืองปัจจุบัน (เมษายน) ****** แถมฟรี เทคนิคการสอบสัมภาษณ์** สามารถติดต่อสอบถามเพิ่มเติมได้ที่ Line: @book99 หรือ คลิ๊กที่นี้ |
| เงื่อนไขอื่นๆ |
- หนังสือ E-BOOK แบบไฟล์ .PDF จัดส่งให้ลูกค้าทาง EMAILหรือ Line เท่านั้น สินค้าจัดส่งหลังชำระสินค้าและแจ้งยอดสำเร็จ 5-10 นาที หมายเหตุ: สินค้าแบบเก็บเงินปลายทางไม่ต้องแจ้งชำระเงิน รอยืนยันรายการจากทีมงาน |
| Tags |
วิธีการชำระเงิน
ชำระเงินผ่านธนาคาร
ชำระเงินด้วยการ Scan QR



นโยบายการเปลี่ยนหรือคืนสินค้า
หากสินค้าที่คุณลูกค้าได้รับมีการจัดส่งผิดพลาด ให้ลูกค้าแจ้งเข้ามาได้ทุกๆช่องทางของการติดต่อเรา
ระยะเวลาที่ลูกค้าสามารถแจ้งการเปลี่ยนคืนสินค้าหรือคืนเงิน ต้องอยู่ภายใน 1-3 วันหลังจากได้รับของจากร้าน
หากร้านค้ามีการจัดส่งผิดพลาด สินค้าทุกชิ้นต้องอยู่ในสภาพดีและทำการส่งกลับให้ร้านเพื่อขอคืนเงินหรือสั่งสินค้าใหม่
| - ไม่มีตัวเลือก - |
|
|
| คงเหลือ | ชิ้น | |
| จำนวน (ชิ้น) |
- +
|
|
|
ไม่มีสินค้าที่เลือก
กรุณาเลือกแบบสินค้าก่อนสั่งซื้อ
ซื้อเลย หยิบลงตะกร้า คุณมีสินค้าชิ้นนี้ในตะกร้า 0 ชิ้น
|
||
 Medeebooks
Medeebooks

อีเมล : nichatshop@gmail.com
TOP เลื่อนขึ้นบนสุด






